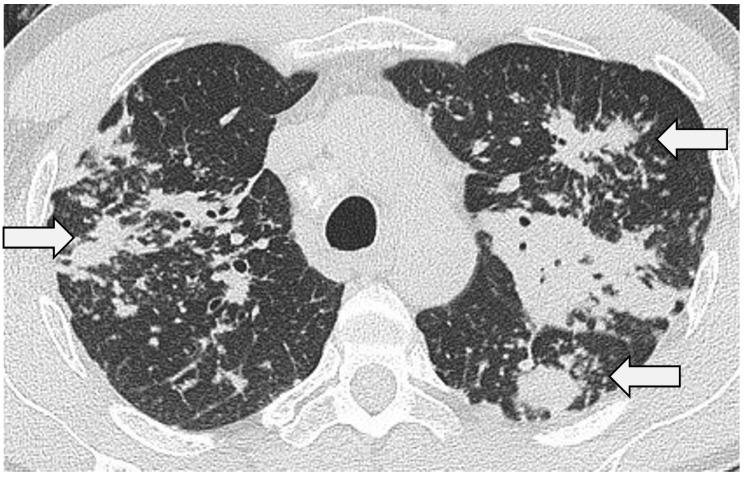

肺结节病的影像学——综述
Imaging of Pulmonary Sarcoidosis-A Review.
作者信息
Bailey Georgina L, Wells Athol U, Desai Sujal R
机构信息
Department of Radiology, Royal Brompton Hospital, London SW3 6NP, UK.
The Interstitial Lung Disease Unit, Royal Brompton Hospital, London SW3 6NP, UK.
出版信息
J Clin Med. 2024 Jan 31;13(3):822. doi: 10.3390/jcm13030822.
Sarcoidosis is the classic multisystem granulomatous disease. First reported as a disorder of the skin, it is now clear that, in the overwhelming majority of patients with sarcoidosis, the lungs will bear the brunt of the disease. This review explores some of the key concepts in the imaging of pulmonary sarcoidosis: the wide array of typical (and some of the less common) findings on high-resolution computed tomography (HRCT) are reviewed and, with this, the concept of morphologic/HRCT phenotypes is discussed. The pathophysiologic insights provided by HRCT through studies where morphologic abnormalities and pulmonary function tests are compared are evaluated. Finally, this review outlines the important contribution of HRCT to disease monitoring and prognostication.
结节病是典型的多系统肉芽肿性疾病。最初被报道为一种皮肤疾病,现在很清楚的是,在绝大多数结节病患者中,肺部会首当其冲受到疾病影响。本综述探讨了肺结节病影像学中的一些关键概念:回顾了高分辨率计算机断层扫描(HRCT)上一系列典型(以及一些不太常见)的表现,并据此讨论了形态学/HRCT表型的概念。评估了通过比较形态学异常和肺功能测试的研究,HRCT所提供的病理生理学见解。最后,本综述概述了HRCT对疾病监测和预后评估的重要贡献。